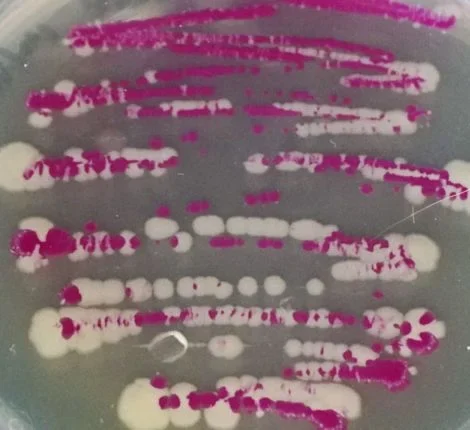
space bacteria (1) A microscopic close-up of bacteria cells

Commencement
Celebrating Graduation Season
See some highlights from the Fall 2025 commencement ceremonies.
News

Headlines from Florida
With the MOMitor™ app, Florida mothers have better maternal care right at their fingertips
Common drug may help HIV medicines work faster and reduce inflammation
A giant LEAP toward faster, smarter genetic testing for cancer
Internet, lack of trust threatens patient-doctor bond
Most parents keep youth sports dreams in check, study finds
Florida in the News
National Geographic How Gen Z is fighting back against brain rot
The Washington Post You might hate these companies' ads. That's the point.
The New York Times Could weight loss drugs turn fat cats into svelte Ozempets?
The Conversation Sugar starts corroding your teeth within seconds – Here's how to protect your pearly whites from decay
Gizmodo This microbe 'plays dead' in NASA clean rooms, and we may have sent it to Mars
Don't Miss a Moment
Every day, the people and programs at the University of Florida solve problems, change lives and widen our view of what’s possible. See what our work means for you.
Happening at Florida
Follow Florida
Join Us
Whether you’re a future student, an alumnus, a potential faculty or staff member or a proud Floridian, there’s a home for you here.